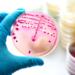

Κικίλιας: «Η κρίση στη Μέση Ανατολή επηρεάζει τρόφιμα, ενέργεια, μεταφορές»
«H γεωπολιτική ανάφλεξη στη Μέση Ανατολή και οι εξελίξεις στα Στενά του Ορμούζ τα συμπαρασύρουν όλα -παραγωγή, βιομηχανικά προϊόντα, πετρελαιοειδή και τα υποπαράγωγά τους, τρόφιμα, τα εισιτήρια- όχι μόνο στη χώρα μας, αλλά σε ολόκληρο τον πλανήτη», δήλωσε ο υπουργός Ναυτιλίας και Νησιωτικής Πολιτικής Βασίλης Κικίλιας, σε συνέντευξή του στο OPEN, επισημαίνοντας ότι οι αυξήσεις στην τιμή του πετρελαίου έως και 10% μέσα σε λίγα 24ωρα, εντείνει τον διεθνή προβληματισμό για τις μεταφορές και τις τιμές των προϊόντων.
«Με ανησυχεί πολύ η κατάσταση. Δεν υπάρχει καμία αμφιβολία ότι στη διεθνή σκακιέρα γίνεται μια προσπάθεια. Το Ισραήλ αισθάνεται ότι απειλείται – απειλείται η ύπαρξή του από το καθεστώς των Μουλάδων στο Ιράν. Δεν είναι μόνο οι βομβαρδισμοί στις πυρηνικές εγκαταστάσεις και στη στρατιωτική ηγετική ομάδα. Υπάρχει μια διάχυτη πεποίθηση ότι έχει προκριθεί και αλλαγή καθεστώτος. Δεν βλέπουμε αποκλιμάκωση, όσο κι αν το ευχόμαστε. Αντιθέτως, βλέπουμε καθαρές πολεμικές επιχειρήσεις σε εξέλιξη. Ο Πρωθυπουργός μίλησε με τον Ισραηλινό ομόλογό του. Η απειλή που διατυπώνεται από το καθεστώς στο Ιράν απέναντι στην ύπαρξη του κράτους του Ισραήλ, είναι ευθεία και σοβαρή» τόνισε ο κ. Κικίλιας.
Για τους Έλληνες που είτε εργάζονται, είτε αυτό το διάστημα βρίσκονται ως επισκέπτες στο Ισραήλ -και ενδεχομένως και στο Ιράν– ο υπουργός υπογράμμισε ότι η κυβέρνηση επεξεργάζεται σχέδια, βάσει της εξέλιξης των επιχειρήσεων. Ο υπουργός επιβεβαίωσε ότι ο Θάλαμος Επιχειρήσεων του Υπουργείου Ναυτιλίας και Νησιωτικής Πολιτικής και η ηγεσία του Λιμενικού Σώματος – Ελληνικής Ακτοφυλακής έχουν αποστείλει, ήδη, τρία ειδικά σήματα με σαφείς οδηγίες στα πλοία με ελληνική σημαία ή σε ελληνόκτητα πλοία που βρίσκονται εντός ή γύρω από τα Στενά του Ορμούζ, επισημαίνοντας ότι «πάνω από όλα είναι η προστασία των ναυτικών μας και των πλοίων μας».
Σχετικά με την ετοιμότητα του Λιμενικού Σώματος, ο Βασίλης Κικίλιας επιβεβαίωσε ότι η εντολή για διαρκή επιχειρησιακή ετοιμότητα έχει δοθεί από τον Πρωθυπουργό και αφορά όλα τα Σώματα Ασφαλείας και τις Ένοπλες Δυνάμεις, σημειώνοντας ότι «οι συνθήκες είναι δυσμενείς και δεν παρατηρείται προς το παρόν αποκλιμάκωση».
Oι επιπτώσεις της κρίσης Ισραήλ – Ιράν στην ελληνική οικονομία: Ενέργεια, τουρισμός και μακροοικονομικές πιέσεις
Η κρίση στη Μέση Ανατολή μπορεί να συμπαρασύρει το παγκόσμιο οικονομικό σύστημα – και ιδιαίτερα τις πιο εξαρτημένες, μικρού και μεσαίου μεγέθους οικονομίες όπως αυτή της Ελλάδας.
Η νέα αναζωπύρωση της έντασης στη Μέση Ανατολή και ο ανοικτός πόλεμος του Ισραήλ με το Ιράν, δημιουργεί έναν νέο γεωπολιτικό κλυδωνισμό που απειλεί να συμπαρασύρει το παγκόσμιο οικονομικό σύστημα – και ιδιαίτερα τις πιο εξαρτημένες, μικρού και μεσαίου μεγέθους οικονομίες όπως αυτή της Ελλάδας. Η διεθνής κοινότητα παρακολουθεί με ανησυχία τις εξελίξεις, καθώς η αβεβαιότητα εντείνεται γύρω από την πιθανότητα στρατιωτικής κλιμάκωσης.
Στο επίκεντρο της κρίσης βρίσκεται το Στενό του Ορμούζ, το οποίο διακινεί περίπου το 21% του παγκόσμιου πετρελαίου. Η πιθανότητα διακοπής ή διατάραξης των μεταφορών από αυτό το κρίσιμο πέρασμα αποτελεί έναν από τους βασικούς παράγοντες αστάθειας που έχουν οδηγήσει σε εκτίναξη των τιμών του πετρελαίου. Το Brent ξεπέρασε τα 75 δολάρια το βαρέλι, ενώ το αμερικανικό WTI κινείται στα 74 δολάρια, με τους αναλυτές να προειδοποιούν ότι, σε περίπτωση επιδείνωσης της κατάστασης, οι τιμές μπορεί να φτάσουν ή και να ξεπεράσουν τα 120 δολάρια το βαρέλι.
Το κόστος ενέργειας
Για την Ελλάδα, που παραμένει καθαρός εισαγωγέας ενέργειας, ένα τέτοιο σενάριο σημαίνει άμεσο πλήγμα τόσο στην ενεργειακή της ασφάλεια όσο και στις πληθωριστικές της ισορροπίες. Ήδη οι λιανικές τιμές καυσίμων έχουν αρχίσει να καταγράφουν ανοδικές τάσεις. Την Παρασκευή 13 Ιουνίου, η μέση τιμή για την αμόλυβδη 95 οκτανίων ήταν πανελλαδικά στα 1,737 ευρώ το λίτρο, ενώ το πετρέλαιο κίνησης διαμορφώθηκε στα 1,480 ευρώ. Οι τιμές διυλιστηρίου, σύμφωνα με τα ΕΛ.ΠΕ και τη Motor Oil, ήταν αντίστοιχα 1.268 ευρώ/m³ για την αμόλυβδη βιοαιθανόλης και στα 1.032 ευρώ/m³ για το diesel αυτοκινήτων. Οι τιμές αυτές θα αυξηθούν αισθητά από αύριο.
Σύμφωνα με το Διεθνές Νομισματικό Ταμείο, κάθε αύξηση 10% στην τιμή του πετρελαίου οδηγεί σε αύξηση του πληθωρισμού κατά 0,4 ποσοστιαίες μονάδες. Αν η διεθνής αστάθεια παραταθεί, η ελληνική κυβέρνηση θα βρεθεί μπροστά σε προβλήματα. Ο πληθωρισμός, που άρχισε να αποκλιμακώνεται στα τέλη του 2024, κινδυνεύει να πάρει ξανά την ανιούσα. Αφενός, λόγω της αύξησης των τιμών ενέργειας που θα επιβαρύνει άμεσα τους λογαριασμούς των νοικοκυριών και το κόστος παραγωγής για τις επιχειρήσεις· αφετέρου, λόγω του συνολικού κόστους μεταφορών, πρώτων υλών και υπηρεσιών ωθεί ανοδικά το γενικό επίπεδο τιμών. Σε περίπτωση παρατεταμένης κρίσης, με τις τιμές του πετρελαίου σταθερά πάνω από τα 100 δολάρια ανά βαρέλι, οι κίνδυνοι για έναν νέο κύκλο στασιμοπληθωρισμού – δηλαδή ταυτόχρονης αύξησης τιμών και επιβράδυνσης της ανάπτυξης – είναι υπαρκτοί. Σε μακροοικονομικό επίπεδο, το μεγαλύτερο βάρος της κρίσης αναμένεται να φανεί στον εμπορικό ισοζύγιο της χώρας, το οποίο είναι ήδη ελλειμματικό. Η Ελλάδα βασίζεται κατά κύριο λόγο σε εισαγωγές για την κάλυψη των ενεργειακών της αναγκών, κυρίως μέσω LNG και πετρελαίου. Σε συνθήκες παγκόσμιας αναταραχής, όχι μόνο αυξάνονται οι τιμές, αλλά και περιορίζεται η δυνατότητα έγκαιρης και σταθερής προμήθειας.
Η πορεία του τουρισμού
Ιδιαίτερα έντονος θα είναι ο αντίκτυπος μιας παρατεταμένης σύρραξης και στον τομέα του τουρισμού, έναν από τους ισχυρότερους μοχλούς της ελληνικής οικονομίας. Το Ισραήλ, παρότι δεν συγκαταλέγεται στις μεγάλες χώρες δεξαμενές τουριστών, παρουσιάζει τα τελευταία χρόνια θεαματική άνοδο: για τη θερινή περίοδο 2025 (Μάρτιος – Οκτώβριος) είχαν προγραμματιστεί πάνω από 1 εκατομμύριο αεροπορικές θέσεις από το Ισραήλ προς την Ελλάδα, αυξημένες κατά 41% σε σχέση με το 2024. Ήδη μέχρι τα μέσα Ιουνίου, πάνω από 83.000 Ισραηλινοί είχαν ταξιδέψει στην Ελλάδα με την Aegean Airlines, καταδεικνύοντας την αναπτυξιακή δυναμική αυτής της αγοράς. Η κλιμάκωση, ωστόσο, της στρατιωτικής σύγκρουσης επηρεάζει άμεσα. Οι ακυρώσεις ταξιδιών, είτε λόγω κυβερνητικών περιορισμών είτε εξαιτίας ανησυχιών των ίδιων των ταξιδιωτών, έχουν ήδη ξεκινήσει, σύμφωνα με κύκλους του τουριστικού κλάδου.
Πέραν της μείωσης στις αφίξεις Ισραηλινών τουριστών, οι επιπτώσεις της κρίσης Ισραήλ–Ιράν στον ελληνικό τουρισμό διατρέχουν ευρύτερο φάσμα και απειλούν να δημιουργήσουν ένα κλίμα γενικευμένης ανασφάλειας που επηρεάζει την ελκυστικότητα της χώρας ως προορισμού. Ο παράγοντας της περιφερειακής αστάθειας, ο οποίος επηρεάζει την αντίληψη των ταξιδιωτών από τρίτες χώρες για την ασφάλεια στην ευρύτερη ανατολική Μεσόγειο, δεν πρέπει να υποτιμάται. Παρότι η Ελλάδα δεν συμμετέχει στη σύγκρουση και δεν αποτελεί στόχο, η γεωγραφική της εγγύτητα στη Μέση Ανατολή αρκεί για να συμπαρασυρθεί στη γενικότερη εικόνα «επικινδυνότητας». Ιδιαίτερα οι αγορές μακρινών χωρών, όπως οι ΗΠΑ, ο Καναδάς, η Αυστραλία ή η Κίνα, έχουν περιορισμένη διαφοροποίηση αντίληψης ανάμεσα σε γειτονικές γεωγραφικά περιοχές. Αυτό σημαίνει πως η κρίση μπορεί να οδηγήσει σε πτώση των κρατήσεων όχι μόνο από το Ισραήλ, αλλά και από διεθνείς επισκέπτες που φοβούνται αναταραχές ή δυσκολίες σε ενδεχόμενη διαφυγή.
Η ελληνική ναυτιλία
Η ελληνική ναυτιλία, που αποτελεί έναν από τους βασικούς παράγοντες τόνωσης του ΑΕΠ και των εξαγωγών υπηρεσιών, βιώνει μια διπλή επίδραση. Από τη μία πλευρά, οι ναύλοι σε μεταφορές LNG, πετρελαίου και εμπορευματοκιβωτίων κινούνται ανοδικά, ενισχύοντας προσωρινά τα έσοδα των εφοπλιστών. Από την άλλη, η αβεβαιότητα ως προς την ασφάλεια των θαλάσσιων οδών, ειδικά στη Μέση Ανατολή, έχει προκαλέσει αύξηση των ασφαλίστρων, καθυστερήσεις και ανακατεύθυνση φορτίων σε δρομολόγια μεγαλύτερου κόστους και χρόνου. Το Στενό του Ορμούζ, σημείο-κλειδί για τις παγκόσμιες ενεργειακές ροές, βρίσκεται στο επίκεντρο αυτής της γεωοικονομικής σκακιέρας. Οι Έλληνες εφοπλιστές, που ελέγχουν περίπου το 25% του παγκόσμιου στόλου μεταφοράς υγροποιημένου φυσικού αερίου (LNG) και σχεδόν το 30% του στόλου μεταφοράς αργού πετρελαίου, καλούνται να διαχειριστούν υψηλό ρίσκο. Αν και οι αυξημένοι ναύλοι ενδέχεται να προσφέρουν πρόσκαιρα οφέλη, μια ευρύτερη γεωπολιτική σύρραξη θα μπορούσε να οδηγήσει σε σοβαρές δυσλειτουργίες στην εφοδιαστική αλυσίδα – με κόστος που δύσκολα απορροφάται από τους μεταφορείς ή τους τελικούς καταναλωτές.
Κίνδυνος επιβράδυνσης
Οι προαναφερόμενες επιπτώσεις της σύρραξης Ιράν – Ισραήλ που εκτείνονται από την ενεργειακή ακρίβεια έως την επιβράδυνση του τουρισμού και την αναστάτωση στις μεταφορές, δημιουργούν τις προϋποθέσεις για επιβράδυνση της οικονομικής δραστηριότητας. Ταυτόχρονα, η αύξηση των τιμών του πετρελαίου και του φυσικού αερίου ενδέχεται να αναζωπυρώσει τις πληθωριστικές πιέσεις, τη στιγμή που η χώρα μόλις είχε αρχίσει να αποκλιμακώνει τον πληθωρισμό μετά την περίοδο ενεργειακού σοκ των ετών 2022–2023. Παρότι οι προβλέψεις της Ευρωπαϊκής Επιτροπής για την Ελλάδα διατηρούσαν έναν συγκρατημένα αισιόδοξο τόνο –με αναμενόμενη αύξηση του ΑΕΠ κατά 2,3% για το 2025 και 2,2% για το 2026– η ραγδαία αλλαγή των συνθηκών θα μπορούσε να οδηγήσει σε αναθεώρηση αυτών των στόχων. Σύμφωνα με τις εαρινές προβλέψεις της Ευρωπαϊκής Επιτροπής, ο πληθωρισμός στην Ελλάδα θα ήταν στο 2,8% το 2025 και στο 2,3% το 2026. Όμως, οι νέες εξελίξεις απειλούν να ανατρέψουν την πορεία αποκλιμάκωσης του πληθωρισμού, ιδίως σε περίπτωση που οι τιμές του πετρελαίου παραμείνουν σε υψηλά επίπεδα για παρατεταμένο διάστημα.
Τα προβλήματα για την ΕΚΤ
Η κρίση Ισραήλ–Ιράν και οι επιπτώσεις της στις τιμές ενέργειας και στον πληθωρισμό δημιουργούν μια νέα πρόκληση για τη νομισματική πολιτική της Ευρωπαϊκής Κεντρικής Τράπεζας (ΕΚΤ). Η βασική αποστολή της ΕΚΤ είναι η διατήρηση της σταθερότητας των τιμών, με στόχο πληθωρισμό κοντά αλλά κάτω από το 2%. Εάν η κρίση στη Μέση Ανατολή διατηρήσει τις τιμές του πετρελαίου και του φυσικού αερίου σε υψηλά επίπεδα για μεγάλο χρονικό διάστημα, τότε θα υπάρξει αναζωπύρωση του πληθωρισμού, κυρίως μέσω της ενέργειας και των μεταφορικών κόστους. Αυτό ενδέχεται να αναγκάσει την ΕΚΤ να αναστείλει προγραμματισμένες μειώσεις επιτοκίων που συζητούνταν για το δεύτερο εξάμηνο του 2025. Η κρίση επίσης επηρεάζει τη συναλλαγματική ισοτιμία ευρώ–δολαρίου. Σε περιόδους έντονης γεωπολιτικής αβεβαιότητας, οι αγορές συχνά στρέφονται στο δολάριο ως ασφαλές καταφύγιο, κάτι που ήδη έχει γίνει τις τελευταίες 48 ώρες, γεγονός που οδηγεί σε υποτίμηση του ευρώ. Με την σειρά της η αποδυνάμωση του ευρώ κάνει τις εισαγωγές ενέργειας πιο ακριβές για τις χώρες της ευρωζώνης και επιτείνει τις πληθωριστικές πιέσεις.